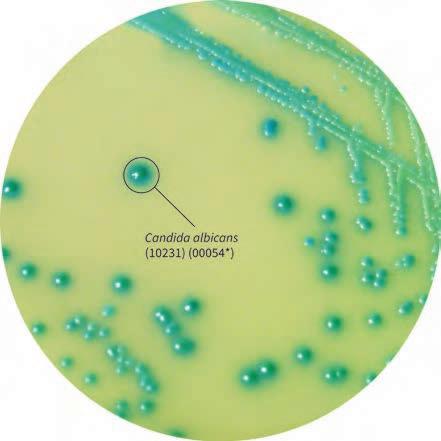
显色培养基教程,显色培养基用途

大肠杆菌O157的检测
大肠杆菌O157:H7与人类的出血性肠炎和溶血性尿毒综合征有关。尽管大规模爆发非常罕见,但症状却很严重,甚至导致死亡。在英国,已推荐对所有腹泻患者的粪便进行O157的检查。针对大肠杆菌O157的显色培养基市面上已有好几款,大部分基于相似的原理:依靠对山梨醇和/或鼠李糖的不发酵,以及缺少β-葡萄糖醛酸酶活性。这些生化标志物,加上选择因子,能帮助将大部分大肠杆菌O157菌株同非致病性大肠杆菌和其他共生菌区分开来。也有的显色培养基使用第二种显色底物(如或β半乳糖苷酶),以突出大肠杆菌O157的存在。
有人曾对大肠杆菌O157显色培养基的性能进行评估,发现它对识别大肠杆菌O157:H7的灵敏度和特异性很高,但对于许多其他产Vero毒素的大肠杆菌血清型,如大肠杆菌O26(该菌株产β-葡萄糖醛酸酶),则不够可靠。要检测所有产Vero毒素的大肠杆菌菌种,还需要采用另外的策略来证实粪便中毒素的存在,如免疫学技术或核酸扩增技术检测毒素的基因。

图. HiMedia大肠杆菌O157显色培养基(货号MV1575A)
酵母的检测和鉴别
已有好几种显色培养基用于检测酵母,这些显色培养基和传统培养基(如沙氏琼脂)相比,被证明在鉴别酵母不同物种上具有更优异的性能。这些显色培养基的共同原理是纳入了β氨基己糖苷酶,使得对于最常见的和具有临床重要意义的白色念珠菌,能够被鉴别和鉴定出来。
有人报道过,和传统的芽管形成试验相比,以β氨基己糖苷酶活性检测为基础的显色培养基,对白色念珠菌的检测是灵敏的,更为特异的,较少主观性,且更为快速。基于这个原因,加上成本分析,作者得出结论,分离酵母的显色培养基比传统培养基在经济上更有优势。
显色培养基通常可将好几种不同的念珠菌物种区分开来,但也存在一定局限。例如,临床样本中遇到的光滑念珠菌,缺乏特异性的显色标志物。另一个局限是难以区分都柏林念珠菌和白色念珠菌。它们都具有β氨基己糖苷酶活性。有人将Pal's的培养基与显色培养基合并,它可以刺激都柏林念珠菌产生厚膜孢子,形成粗糙菌落,从而与白色念珠菌相区分。
也有人进行补充的生化试验或血清学试验,以辅助显色培养基。例如,乳胶凝集试验可用于特异性的鉴定克柔念珠菌和都柏林念珠菌的菌落。海藻糖吸收试验也可快速鉴定光滑念珠菌。

图. HiMedia念珠菌显色培养基(左:货号M1297A;右:货号M1297AR)
无乳链球菌的检测
无乳链球菌(B族链球菌)是一种可导致新生儿死亡的感染性疾病病因。一些国家推荐对于孕妇的阴道拭子进行这种病原体的常规筛查。B族链球菌显色培养基可用于检测无乳链球菌。在一项对134个阴道拭子B族链球菌进行检测的研究中,显色培养基表现出比血平板更高的特异性和灵敏度。在一项有737个样本的大型研究中,有人报道了B族链球菌显色培养基比Granada培养基或选择性血平板具有更高的灵敏度。在孵育48h后,它使菌株的回收率增加,作者还强调在分离之前,应使用选择性增菌肉汤。

图.HiMedia的B族链球菌显色培养基(货号:M1966)。菌落为无乳链球菌菌落。
结论和展望
在许多研究中,显色培养基被证实其对传统培养基所具有的优势,即更出色的检测率,及对混合菌群的鉴别能力。包含显色底物的显色培养基价格毫无疑问地要比传统培养基高,但它可被与可疑菌株验证和平板制备相关的试剂消耗和劳动时间的减少所抵消。
由于这些因素,在诊断实验室中显色培养基的应用越来越普遍。很可能在未来几年内,针对更多病原体的显色培养基会被开发出来。针对食品中弧菌和弯曲菌的显色培养基,也在被评估用于临床诊断。对MRSA等耐药菌筛查的显色培养基则进一步推动了针对其他耐药菌的显色培养基的应用和开发。几乎所有商用显色培养基都依赖于检测糖苷酶、磷酸酶或酯酶活性。大多数细菌病原体产生丰富的肽酶,但这些肽酶到目前为止仍未开发。对这些酶活性的识别和适当显色底物的设计,将使得针对其他致病菌(例如军团菌)的更多显色培养基的开发成为可能。
参考文献
J.D. Perry and A.M. Freydie`re. The application of chromogenic media in clinical microbiology.Journal of Applied Microbiology. 2007,103: 2046–205